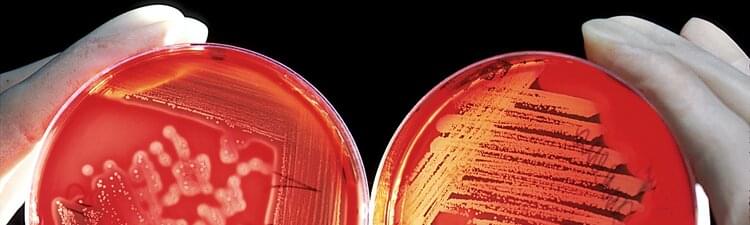

Biólogo
Descripción del trabajo del biólogo

El biólogo es un científico que estudia los mecanismos celulares y moleculares y los procesos químico-físicos que se producen en los seres vivos (humanos, animales, plantas y bacterias), su genética y su relación con el medio ambiente externo, incluidos los procesos de desarrollo, evolución e interacción con otros organismos.
¿Pero qué hace exactamente un biólogo?
El biólogo observa la naturaleza y la vida en ella, experimenta en el laboratorio, utiliza métodos de investigación para comprender cómo funcionan los organismos a nivel molecular y celular y estudia los procesos vitales.
Una de las tareas del biólogo es identificar y comprender las reacciones químicas biológicas que mantienen al organismo vivo (respiración celular, metabolismo, fotosíntesis clorofílica, etc.) y las estructuras moleculares que se forman para mantener el ambiente dentro del organismo estable y en equilibrio (homeostasis).
Para ello, los biólogos analizan células, tejidos y muestras de materiales biológicos bajo el microscopio y realizan análisis moleculares, microbiológicos y bioquímicos de compuestos o sustancias individuales.
La biología es una ciencia que tiene varios campos de aplicación: por ejemplo, los graduados en biología suelen trabajar en el sector de la salud, los hospitales y los laboratorios de análisis clínicos.
Las actividades del biólogo clínico se realizan principalmente en el laboratorio: el biólogo realiza análisis microbiológicos, genéticos y bacteriológicos del material biológico tomado (por ejemplo, muestras de sangre) para el diagnóstico o la prevención de enfermedades, o con fines de investigación, para el ensayo de nuevos medicamentos y vacunas.

Otra área en la que la figura del biólogo es bastante común es el sector de la alimentación, donde se puede encontrar empleo como biólogo alimentario o biólogo nutricionista. El biólogo alimentario trabaja para las empresas de alimentos: su tarea es realizar análisis y control de calidad de las materias primas, los productos semiacabados y acabados para verificar que los métodos de preparación, almacenamiento y transporte de los alimentos cumplen con las normas de higiene y de HACCP.
Se trata de análisis preventivos que permiten identificar los posibles riesgos para la salud de los consumidores.
El biólogo nutricionista, por otro lado, se ocupa directamente de la nutrición humana: evalúa las necesidades nutricionales y energéticas individuales y desarrolla dietas personalizadas, destinadas a proporcionar el suministro de energía adecuado al cuerpo.
Un biólogo también puede trabajar en el sector de los cosméticos, como cosmetólogo: realiza análisis y controles de calidad de productos cosméticos como cremas y labiales y supervisa las diversas etapas de producción, desde las materias primas y la formulación del cosmético hasta la comercialización del producto.
También hay oportunidades de empleo para biólogos en empresas del sector químico-farmacéutico, principalmente en las áreas de análisis de laboratorio y control de calidad de las empresas farmacéuticas.
También hay biólogos que trabajan en el ámbito de la protección del medio ambiente y la protección de la biodiversidad: realizan muestreos y análisis de laboratorio para la agricultura y la industria, por ejemplo para vigilar la presencia de contaminantes en el medio ambiente y el agua o para evaluar el bienestar de los animales en las granjas.
Además, un biólogo puede dedicarse al estudio e investigación de aspectos de la vida marina como biólogo marino.
Otras oportunidades de trabajo son en la investigación o la enseñanza. Los graduados en biología pueden convertirse en profesores de biología en las escuelas, o encontrar empleo como investigadores en universidades, laboratorios y centros de investigación públicos o privados, en equipos con otros científicos y técnicos de laboratorio.
Por ejemplo, los expertos en ciencias de la vida trabajan en investigaciones genéticas, investigaciones sobre el cáncer o investigaciones para la producción de productos biológicos y biodegradables.
Las tareas y deberes del Biólogo

Las tareas del biólogo varían según el contexto de trabajo.
En general, entre las tareas encomendadas a los biólogos están:
- Recopilar datos y muestras
- Realizar análisis microbiológicos de tejidos, materiales y líquidos biológicos
- Realizar análisis químico-biológicos y controles de calidad
- Analizar los datos reunidos por métodos científicos y estadísticos
- Elaborar informes e informes con los resultados de los análisis
- Hacer investigaciones y observaciones en el campo
- Realizar experimentos
- Proporcionar consultoría en el campo biológico
¿Cómo convertirse en biólogo? Entrenamiento y requisitos

Para ser biólogo necesitas un título en Biología, Ciencias Biológicas o similar.
Durante el curso de los estudios se abordan temas como la química, la genética molecular, la citología, la histología, la taxonomía, la botánica, la zoología, la ecología y otras materias científicas (matemáticas, física, estadística, informática).
La formación del biólogo suele incluir también un período de práctica o pasantía en el laboratorio, en el que se familiariza con los métodos de trabajo y con el equipo y los instrumentos propios de un laboratorio de análisis (microscopio, pH-metro, incubadoras, equipos de electroforesis, mineralizador para el análisis de metales pesados, etc.), y en el que aprende a trabajar en equipo.
También hay varias especializaciones de posgrado, que dan la oportunidad de adquirir conocimientos y cualificaciones específicas para trabajar en determinados campos: por ejemplo, en genética, ecología, biología marina, cosmetología o biotecnología.
Independientemente del campo de especialización, el biólogo debe cumplir las normas legales y deontológicas que rigen la profesión, incluidas las normas de acceso a la profesión y el código de ética de la profesión de biólogo.
También es importante estar constantemente actualizado, participando en conferencias, leyendo revistas y publicaciones científicas en el campo, comparando y colaborando con otros biólogos, científicos y estudiosos de las ciencias de la vida.
Competencias de un biólogo
Las principales competencias que debe tener un biólogo son:
- Conocimiento de métodos y técnicas de investigación biológica
- Capacidades de recopilación y análisis de datos
- Conocimientos operacionales en análisis de laboratorio químico-biológico
- Capacidad de realizar investigaciones y experimentos con método científico
- Capacidad de utilizar instrumentos y equipo de laboratorio
- Curiosidad y habilidades de observación
- Capacidades analíticas y de resolución de problemas
- Precisión y exactitud
- Capacidad de trabajar en equipo
Oportunidades de empleo y carrera del Biólogo
Después de completar sus estudios, el biólogo puede encontrar empleo en diferentes campos y emprender diferentes carreras.
Quien trabaja como técnico de laboratorio puede llegar a ser responsable de los análisis de laboratorio (en el ámbito clínico, microbiológico, químico-biológico, ambiental, etc.), pero un biólogo también puede llegar a ser responsable del control de calidad en las empresas alimentarias, farmacéuticas o en las plantas de producción de cosméticos.
Puede participar en proyectos de investigación - por ejemplo, en los campos de la biología molecular, la genética, la biología marina, la contaminación ambiental - en equipos con otros científicos e investigadores, incluso a nivel internacional, y tomar la iniciativa como Jefe de Equipo o Director de Proyecto de Investigación.
Algunos se dedican a enseñar como profesor de biología y otras materias científicas en la escuela secundaria o en el mundo académico.
Un biólogo también puede optar por trabajar como consultor independiente y colaborar con empresas y organismos, por ejemplo en el ámbito de la protección del medio ambiente, la seguridad alimentaria o la certificación de OGM.
Buenas razones para trabajar como biólogo
La profesión de biólogo es adecuada para aquellos que tienen interés en las ciencias biológicas, son curiosos y atentos al medio ambiente.
La biología es una ciencia que contribuye de manera muy importante al tratamiento y prevención de enfermedades, a la protección del medio ambiente y, en general, a la mejora de las condiciones de vida de los seres humanos, los animales y las plantas, gracias a los avances científicos y a los proyectos de investigación de vanguardia.
Una licenciatura en biología abre la puerta a diferentes oportunidades de carrera - en la investigación, la industria, la clínica o la enseñanza - con interesantes perspectivas profesionales.
El salario del biólogo varía según el contexto de trabajo, y es generalmente más alto para los candidatos con especializaciones, doctorados o calificaciones especiales.
¿Quieres encontrar trabajo?